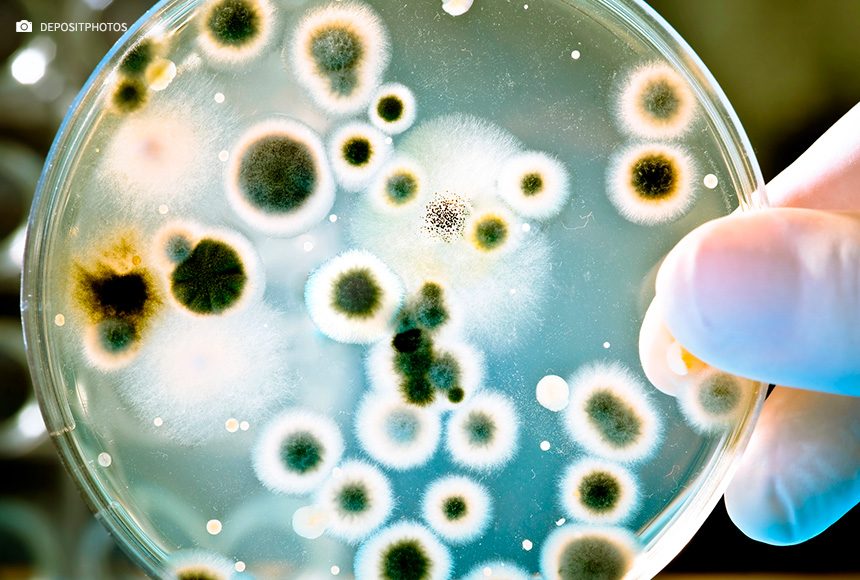

Quando falamos sobre as doenças que mais matam no mundo, é comum que venham à cabeça o câncer, problemas cardíacos ou pulmonares. Mas, de acordo com a Organização Mundial da Saúde (OMS), temos um novo problema: a resistência antibiótica. A estimativa é que a partir de 2050 as bactérias resistentes a antibióticos irão matar, pelo menos, 10 milhões de pessoas por ano, um número maior que o atual de mortes causadas por cânceres.
Essa resistência é adquirida pelo uso inapropriado de antibióticos e pode ser estendida à produção animal e agrícola. Ela é um problema sério e global de saúde, que ocorre quando bactérias não são eliminadas durante o tratamento devido às mutações genéticas que conferem resistência. Dentre os lugares mais suscetíveis, estão os hospitais, nas unidades de terapia intensiva (UTIs), mas também pode acontecer durante tratamentos domiciliares.
Os medicamentos citados pela OMS são os antimicrobianos, que incluem antibióticos, mas também podem ser antivirais, antifúngicos e antiparasitários. Alguns dos mais comuns, quando utilizados de forma inadequada ou em excesso, são: quinolonas, cefalosporinas, penicilina, macrolídeos e tetraciclinas. Além destes, outros antibióticos menos comuns podem colaborar com a seleção de bactérias mais resistentes.
Resistência traz danos à saúde global e a farmacoeconomia
Segundo o Dr. Fernando Henrique Gonçalves, médico intensivista do Hospital VITA, os riscos para a saúde são grandes. “A resistência bacteriana aos antibióticos é, atualmente, um dos problemas de saúde pública mais relevantes, uma vez que muitas bactérias, anteriormente suscetíveis aos antibióticos usualmente utilizados, deixaram de responder a esses mesmos agentes. A resistência aos antibióticos é responsável por consequências clínicas e econômicas graves, relacionadas com o aumento da morbilidade e mortalidade devido ao atraso na administração de tratamentos eficazes contra as infecções causadas por bactérias resistentes”.
Além de agravar o quadro infeccioso, a resistência também põe em risco o tratamento de infecções causadas por vírus, parasitas, fungos e outras enfermidades e até mesmo se torna um fator negativo em procedimentos avançados, como a quimioterapia ou o transplante de órgãos.
Outro setor que é acometido pela resistência é o econômico, pois uma vez que o paciente é internado e os antibióticos não respondem, o valor gasto com medicações tende a aumentar, assim como os gastos com internação. “A hospitalização prolongada e o uso de antibióticos diferentes dos de primeira linha aumentam, e de forma acentuada, os custos com cuidados de saúde, o que constitui um problema particularmente relevante, considerando os recursos finitos que sustentam os sistemas de saúde”, destaca.
Exames moleculares identificam resistência
Saber quais resistências a bactéria possui permite que o tratamento realizado seja assertivo, contribuindo para a saúde da pessoa, além de diminuir o tempo de internação e os gastos com medicamentos que podem não fazer efeito. A Mobius, empresa que desenvolve e comercializa produtos destinados ao segmento de medicina diagnóstica focada na biologia molecular, lançou o kit MDR Direct Flowchip Kit, que realiza a identificação de microorganismos multirresistentes por PCR multiplex e hibridização reversa, sendo a detecção de cinco espécies bacterianas (S. aureus, K. pneumoniae, P. aeruginosa, E. coli e A. baumannii) e 56 marcadores de resistência que incluem os principais mecanismos do tipo enzimático.
“É necessário saber que alguns pacientes, principalmente aqueles internados ou com internamento hospitalar recente, podem ser colonizados por bactérias multirresistentes, sem significar necessariamente que possuem infecção. Mas a importância de determinar se há tal tipo de colonização impacta em medidas de isolamento de contato, por exemplo, para evitar infecções cruzadas dentro do ambiente hospitalar. Determinar se uma bactéria é multirresistente ou não, é fundamental para o resultado do tratamento. Existem métodos de pesquisa para determinar esse grau de resistência, alguns desses exames são mais simples, mas outros exigem métodos mais sofisticados de acordo com a base molecular da resistência bacteriana, sendo necessário análises genéticas inclusive”, explica o Dr. Fernando.
Como prevenir a resistência?
Há mais de dez anos, a Agência Nacional de Vigilância Sanitária (ANVISA) determinou que antimicrobianos só podem ser vendidos com receita médica no Brasil. Tal ato é uma maneira de garantir que essas medicações só serão utilizadas para tratar infecções bacterianas diagnosticadas por um profissional da saúde, impedindo a automedicação e o consumo desses medicamentos para tratar infecções virais, como por exemplo uma simples gripe.
Evitar a automedicação é uma maneira de prevenir a resistência antibiótica, mas também realizar o tratamento correto, mesmo que apresente melhora antes do fim do ciclo, pois isso garante a eficácia do tratamento. Ainda de acordo com o médico intensivista, uma outra maneira de prevenir a emergência e disseminação das resistências bacterianas, é restringir o consumo de antibióticos na prática veterinária e na produção animal, atividades responsáveis pelo consumo inadequado de muitos antibióticos.
Sobre a Mobius
A Mobius faz parte de um grupo sólido de empresas com mais de 25 anos de atuação e grande expertise no mercado. Desenvolve, produz e comercializa produtos destinados ao segmento de medicina diagnóstica, fornecendo kits para o Diagnóstico Molecular in vitro de doenças infecciosas, oncologia e genética e sorologia, tornando o diagnóstico cada vez mais rápido e preciso.